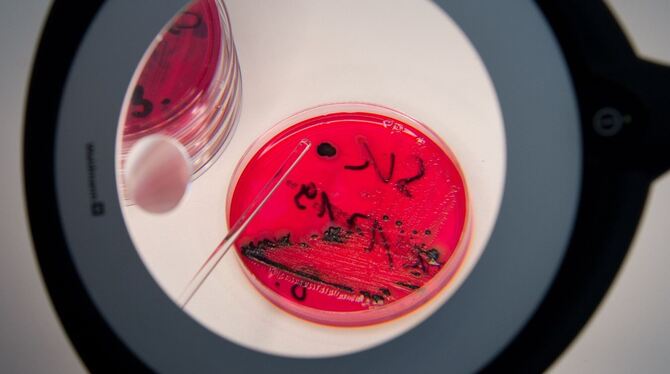

Wegen einer möglichen Salmonellen-Belastung ist italienische Salami der Marke »Rewe Feine Welt« zurückgerufen worden. Von der Wurst mit dem Namen »Salame Felino« in der 80-Gramm-Packung sei ausschließlich Ware mit dem Mindesthaltbarkeitsdatum 14.07.2024 bis einschließlich 21.07.2024 betroffen, teilte die Gabel Vertriebsgesellschaft aus dem westfälischen Lünen mit.
Bei einer routinemäßigen Qualitätskontrolle seien in dem Produkt Salmonellen nachgewiesen worden. Eine Gesundheitsgefährdung könne deswegen nicht ausgeschlossen werden. Wer das entsprechende Produkt gekauft habe, könne es auch ohne Vorlage des Kassenbons zurückgeben und sich sein Geld erstatten lassen.
Eine Salmonellen-Erkrankung äußert sich innerhalb einiger Tage nach der Infektion mit Durchfall, Bauchschmerzen, gelegentlich Erbrechen und leichtem Fieber. Vor allem Säuglinge, Kleinkinder, Senioren und Menschen mit geschwächtem Abwehrsystem können schwerere Krankheitsverläufe entwickeln.
© dpa-infocom, dpa:240627-99-558841/2